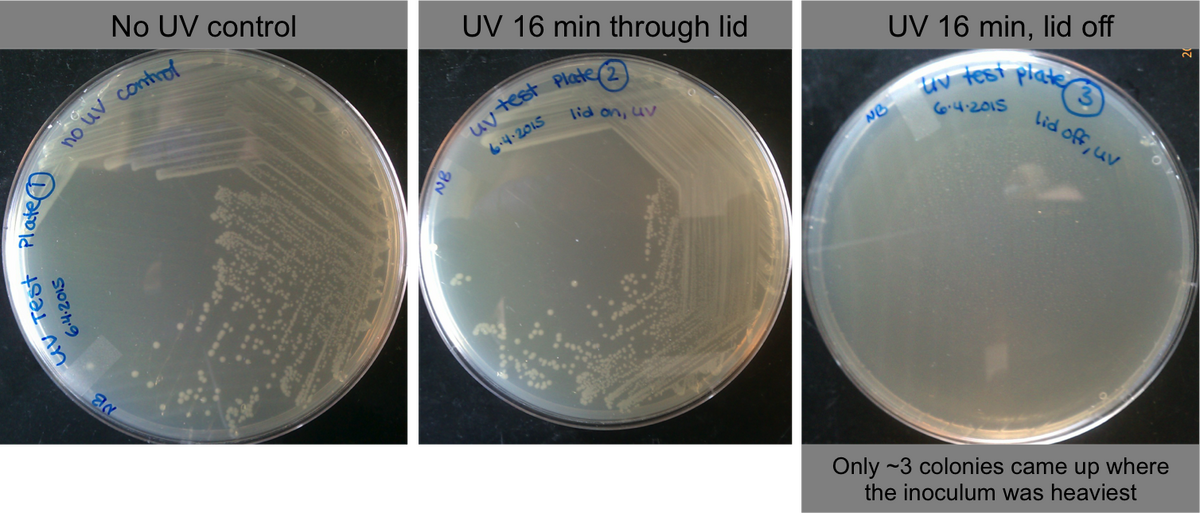

Lidstrom:Sterile Technique
From OpenWetWare
Jump to navigationJump to search
Here is a starting point: BenchFly video
How do bio safety hoods work?
To see how the air flows, you can put a few nuggets of dry ice in a Pyrex jar. Pour water in the jar, and "smoke" will start pouring out. You can move the jar around the hood to see where the smoke goes.
The cabinets in the Lidstrom lab have air pushed into the space from the top. This sheet of air splits to the front and back where it is sucked in. So the area where your wrists are is sucking down.
UV hoods
- UV sterilizes by damaging DNA.
- 16 minutes of full UV exposure is pretty lethal. UV can not penetrate the plastic petri dish lids:
UV exposure kills cells, but cannot penetrate petri dish lids. (source)
Video Example of UV Hood Airflow
<html> <iframe width="420" height="315" src="https://www.youtube.com/embed/U-AC_Rio8UI" frameborder="0" allowfullscreen></iframe> </html>